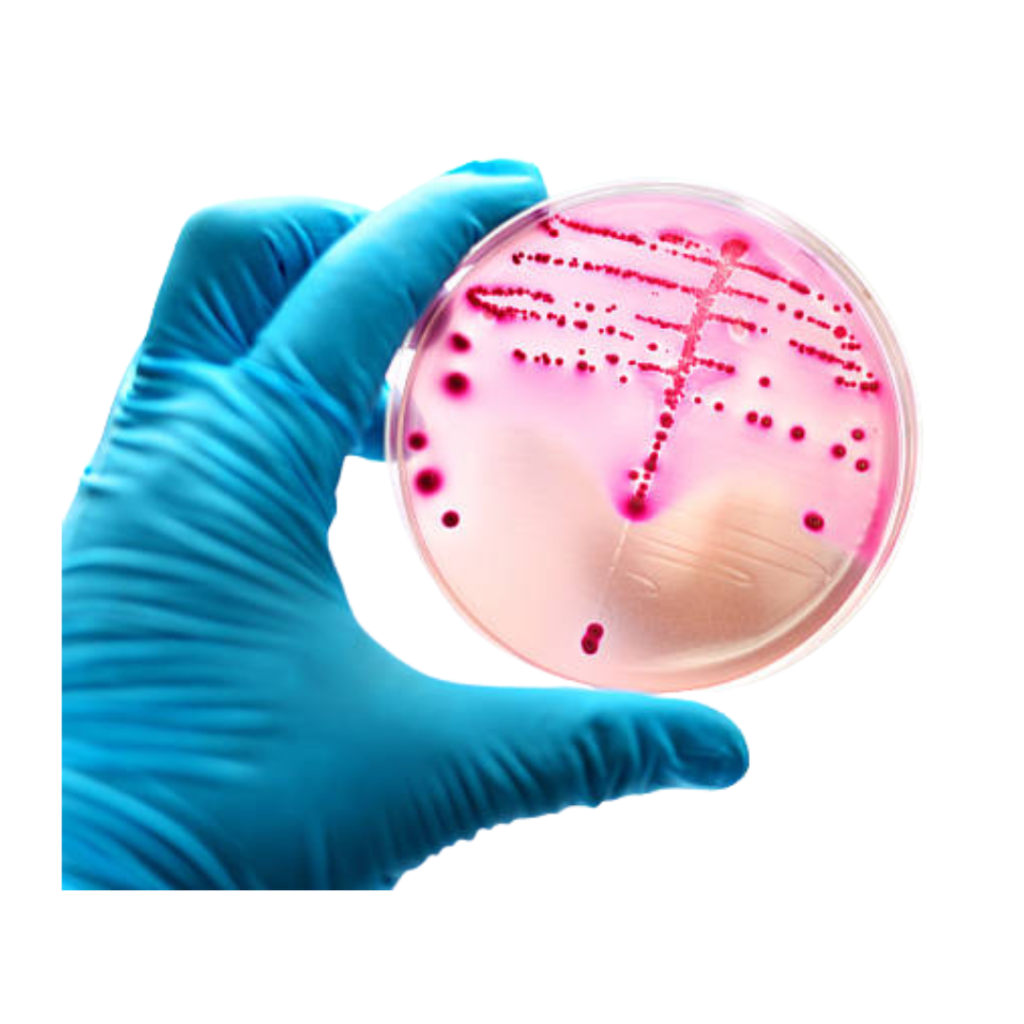

DỊCH VỤ CỦA CHÚNG TÔI
Cung cấp các dịch vụ xét nghiệm chất lượng cao cho thú cưng và động vật nuôi. Cam kết mang đến kết quả xét nghiệm chính xác, hỗ trợ tối đa cho khách hàng trong việc chẩn đoán các bệnh trên heo, gia cầm và thú cưng

PHÂN LẬP-KHÁNG SINH ĐỒ
Phân lập vi khuẩn gây bệnh đường ruột và hô hấp trên lợn, đề xuất kháng sinh phù hợp và kiểm tra mức độ nhạy kháng sinh trong trang trại.
Kiểm tra chỉ tiêu vi sinh mẫu nước thông qua các chỉ số pH, tổng số E. coli, tổng số Coliform, và tổng số vi khuẩn hiếu khí.
REALTIME-PCR
Chẩn đoán các tác nhân gây bệnh (định tính, định chủng và định lượng (nếu có)) thông qua kĩ thuật Realtime – PCR; giải quyết vấn đề và giảm thiểu tối đa thiệt hại ở các trang trại chăn nuôi gia súc – gia cầm


HUYẾT THANH HỌC
Đánh giá hiệu quả tiêm phòng vắc-xin thông qua việc phân tích kết quả dựa trên phương pháp ELISA kết hợp với thông tin tiêm phòng tại các trang trại.